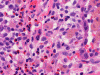

Movat Pentachrome
Movat Pentachrome
| A 60 year-old Asymptomatic
Man with Multiple Nodules in the Lung and Mediastinal Lymphadenopathy. February, 2007, Case 702-1. Home Page |
Katerine Seywerd, M.D., Ravindranauth N. Sawh, M.B., B.S., D.M. Department of Pathology, University of Oklahoma Health Sciences Center, Oklahoma City, OK. Last updated on May 1, 2007
Clinical information: The patient was an asymptomatic, 60 year-old smoking male with a past history laryngeal cancer, status-post chemo- and radiation therapy. He was followed in the clinic for evidence of cancer recurrence. About one year ago, the patient was found to have a distinct coin lesion in the right upper lung lobe and multiple, small to minute, diffuse pulmonary nodules bilaterally. The base of the lung was relatively spared. Mediastinal lymphadenopathy was also demonstrated. A chest CT showed similar findings. An FNA was carried out for suspicion of malignancy on a pleural based nodule but the specimen has only non-diagnostic changes. The patient continued to be followed with chest CTs which demonstrated an increase in number of lung nodules, stable mediastinal lymphadenopathy and an interval development of interstitial fibrosis. He remained asymptomatic. A suspicion of infectious etiology was considered, although malignancy could not be ruled out. A tuberculin test was negative. A wedge biopsy obtained from the right upper lobe lung was performed. The followings are representative images of the biopsy material.
 |
 |
 |
 |
 |
 |
| A. | B. | C. | D. | E. | F. |
 |
 |
|
 |
 |
 |
| G. | H. | I. | J. | K. | L. |
 |
 |
||||
|
M. Movat Pentachrome |
N. Movat Pentachrome |
Histopathology of the case:
At scanning magnification (Panel A), the lung parenchyma is replaced by some coalescing fibrous nodules. The degree of involvement is variable at different fragments (Panel B and C). In the less affected areas, there are some fibrotic thickening of the septa (Panel C). In some areas, the changes are minimal and the pleural appear to be uninvolved (Panel D and E). In low to medium magnifications, these nodules of fibrosis contains a large number of hemosiderin laden macrophages (Panel F and G) admixed with fibrous tissue. The diagnostic tissue, however, is present in areas with increased cellularity. In these areas, there is a background of cells with a moderate amount of cytoplasm and bland nuclei. Some of these nuclei have kidney shape (arrow in Panel H). In some areas, many of the nuclei have a deep nuclear groove that resemble a coffee bean (arrow in Panel I). In the third type of areas, the nuclear grooving is not distinct (Panel J). Prominent eosinophilic infiltrations are almost always present. Immunohistochemistry on CD1a revealed many positive cells (Panel L). Also present in the specimen are multiple small blood vessels with thickened intima (Panel K). A Movat pentachrome stain demonstrates an internal elastic layer in these vessels and confirms that these are arteries (Panel M and N).
Comment:
Histopathologic signature of Langerhans cell histiocytosis, namely kidney shaped or coffee bean shaped, bland nuclei associated with eosinophilic infiltration is not difficult to see in most of the cases. The amount of eosinophilic infiltration and the proportion of cells with nuclear grooving, however, can be quite variable but this problem can usually be overcome by a diligent search. Demonstration of CD1a by immuhonistochemistry or Birbeck granules by electron microscopy will confirm the diagnosis.
| DIAGNOSIS: Langerhans cell histiocytosis of the lung. |
About the special stain used in this case:
Silverman-Movat Pentachrome is a stain that utilizesfive different stain components (orcein, alcian blue, woodstain scarlet, acid fuchsin and Spanish saffron) to aid in the visualization of elastic fibers, mucin and collagen. Orcein allows visualization of elastic fibers in acid-alcohol solution and colors them purple to black. Alcian blue stains acid mucopolysaccharides/mucin blue. Both woodstain scarlet and acid fuchsin are used in combination to stain muscle fibers red with longitudinal myofibrils, cross striations and intercalated discs delineated. Spanish saffron colors connective tissue yellow to yellow-green.
In this case it was utilized for two purposes. Since usual interstitial pulmonary fibrosis was one of the differential diagnosis, this stain can be used to demonstrate coexisting old and young/cellular fibrosis. Old fibrosis would appear yellow and the young fibrosis would appear blue-green (ground substance). It proved to be negative. The second purpose (not originally intended) was to help emphasize the thickened intimal layer seen with the associated vasculopathy.
Discussion:
General Information
Langerhans cells (LCs) are specialized immune cells belonging to the family of dendritic cells which function as antigen presenting cells and migratatory cells in lymphoid and non-lymphoid organs. Related to the monocyte-macrophage system, they arise from the same bone marrow progenitor with specific growth factors influencing differentiation. An accumulation of LCs in tissues can occur as a result of local reaction to inflammatory/neoplastic stimuli as is seen in the lungs of smokers or with certain lymphomas and solid tumors.
Langerhans cells histiocytosis (LCH), formerly known as histiocytosis X and Langerghans cell granulomatosis is a group of disorders characterized by neoplastic growth of cells with phenotypic features of Langerhans cells 1. Typically, the a widely variable amount of eosinophils and chronic inflammatory cells admix with the Langerhans cells. LCH spans a spectrum from a solitary lesion, often known as eosinophilic granuloma, to multiple lesions in an organ, to multiple organ involvement. In the past, the disseminated forms are known as Letterer-Siwe syndrome and Hand-Schüller-Christian syndrome. It is an uncommon disease with a definitive male predilection. The age range is wide but patients with unifocal disease are usually older children or adults. Bone is commonly affected. Disseminated LCH usually affects young children or infants.
Pulmonary Langerhans cells histiocytosis (PLCH), also known as pulmonary eosinophilic or granuloma or pulmonary histiocytosis X, refers to LCH with the pulmonary manifestations as salient clinical features. It is often hard to categorize whether this is a condition with involvement restricted to the lung or part of a systemic LCH. Between 4-20% of PLCH have cystic bone lesions and many case reports have demonstrated involvement of other sites (mediastinal lymph nodes, pituitary gland, skin, heart, gut and brain) 2, 3.
Clinical Features
Clinically, about 90% of individuals with PLHC are smokers who develop disease at 20 to 40 years of age 4. Presenting symptoms may include dyspnea, cough, chest pain, pneumothorax, constitutional symptoms or hemoptysis 4. The physical exam is often unremarkable. Measurment of gas exchange is often more sensitive as opposed to measurement of lung mechanics, which may be normal, obstructive, restrictive or mixed. Progression of disease can lead to pulmonary hypertension, clubbing and cor pulmonary 4. The 5 and 10 year survival rates of 70% and 60% respectively. A worse survival is seen in those with poor respiratory function and older age at diagnosis.
In up to 25%, an abnormal chest x-ray (CXR) may be the only clue to the disease in asymptomatic individuals4. CXR findings include ill-defined nodules and curvilinear/reticular opacities (cysts). (6) Changes are most predominant in mid- to upper lung regions. The lesions are symmetrical with no predilection for central or peripheral lung zones. Costophrenic angles are often spared and lung volumes are normal or increased. Over time the nodules decrease and cystic changes increase. (11) Rarely, findings can include mediastinal lymphadenopathy, solitary pulmonary nodule, consolidative opacities and pleural effusions. CT findings vary according to lung stage, with cysts and nodules found in the majority of patients. A centrilobularpattern with ill-defined nodules centered around the small airways and cysts with uniform wall thickness (diameter <10 mm) are typical. Diagnosis based strictly on CT findings may be difficult in cases where only cysts or only nodules are seen.
Lung perfusion scintigrams may demonstrate abnormal perfusion, greatest in the upper and mid-lungs, but the distribution of reticular and nodular changes does not correlate with the altered lung perfusion. This is consistent with findings of vasculopathy observed in areas of lung not involved by parenchymal nodules.
Pathogenesis
The pathogenesis of LCH is uncertain but no convincing evidence on their relation to commonly seen viruses such as cytomegalovirus or Epstein-Barr virus have been demonstrated. The etiology of PLCH is thought to be an aberrant immune response to cigarette smoke as it is seen mainly in heavy adult smokers 5. Initially, PLCH involves the lungs in a peribronchiolar fashion as would be seen with an inhaled antigen and radiographically there is involvement of upper and mid-lung zones similar to other smoking related lung diseases. Further support comes from studies demonstrating that activated LCs express molecules promoting T-cell activation. Expression of such lymphostimulatory molecules is not seen in normal pulmonary LCs or LCs that collect in other lung disorders. Additionally, LCs are present in increased numbers in the BAL fluid of smokers.
Arguing against smoking as an etiology is lack of association between extrapulmonary LCH lesions and smoking and the poor response to smoking cessation and lesion resolution. Also, only a small number of smokers develop PLCH, suggesting other factors, such as genetic predisposition or environmental factors, play a role.
Pathology
Pathologically, PLCH can be broadly divided into an early or cellular stage and a late or fibrotic stage. Demonstration of LCs is of critical importance for a correct diagnosis. The morphology of LCs is similar to LCH in other organs. LCs are characterized by a deep nuclear groove which lead to “coffee bean-shaped” or “kidney-shaped” nuclei. In most cases, the level of atypia and pleomorphism is low. A moderate amount of amphophilic to weakly eosinophilic cytoplasm is present. The cytoplasmic membrane is indistinct. Eosinophils and chronic inflammatory cells, varying from scant to abundant, are present. Except for a scant frankly pleomorphic cases, the level of pleomorphism and atypia is minimal to low. Eosinophilic abscesses with central necrosis may be present. Immunohistochemically, LCs are similar to their normal counter parts and are positive for CD1a and S100. At the ultrastructural level, Birbeck granules can be demonstrated. For most cases, the diagnosis can be established by histopathologic criteria but these additional features help to confirm the diagnosis.
In the early stage of PLCH, there are interstitial infiltrates composed of LCs, lymphocytes, macrophages, eosinophils, plasma cells and fibroblasts 4. The infiltrates enlarge to form nodules centered on the small airways. Brown pigmented macrophages (smokers macrophages) are present in and around the nodules. Eosinophils tend to localize at the innermost layer of the nodules, where LCs can be most easily found in the thickened interstitium. Associated patchy interstitial and airspace organization or respiratory bronchiolitis may be present. Other smoking related changes are also common. Cavitation often occurs within the nodules which represents either an airway remenant or de novo cavitation as the inflammatory infiltrate enlarges. There is centripetal replacement of the nodules by fibroblasts which produce the classic stellate lesions of PLCH. As the disease progresses, the number of nodules, cavitary granulomas and fibrotic scars increase in number.
In the end stage, the exhausted lesions are predominantly fibrotic and largely depleted of LCs. In some regions, the fibrosis may surround cystic spaces of variable diameter to form large areas of honeycombing. This is especially predominant in the upper lobes. In cases where parenchymal scaring is present, the pulmonary function will be largely compromised. At this stage, both pulmonary function tests and radiologic findings may suggest diffuse lung disease, but biopsy will show stellate fibrotic lesions centered on the terminal airways with no identifiable interstitial inflammation. Pulmonary vasculopathy (in areas of lung remote from parenchymal nodules) is also seen in late stage PLCH. Vasculopathy manifests as intimal fibrosis, medial hypertrophy or luminal obliteration involving both venules and arteries. This may account for pulmonary hypertension seen late in PLCH.
References
Willman CL, Busque L, Griffith BB, Favara BE, McClain KL, Duncan MH, Gilliland DG. Langerhans'-cell histiocytosis (histiocytosis X)--a clonal proliferative disease. N Engl J Med. 1994 Jul 21;331(3):154-60.
Sundar KM, Gosselin MV, Chung HL, Cahill BC. Pulmonary Langerhans cell histiocytosis: emerging concepts in pathobiology, radiology, and clinical evolution of disease. Chest. 2003 May;123(5):1673-83.
Vassallo R, Ryu JH, Colby TV, Hartman T, Limper AH. Pulmonary Langerhans'-cell histiocytosis. N Engl J Med. 2000 Jun 29;342(26):1969-78.
Caminati A, Harari S. Smoking-related interstitial pneumonias and pulmonary Langerhans cell histiocytosis. Proc Am Thorac Soc. 2006 Jun;3(4):299-306.
Vassallo R, Ryu JH, Schroeder DR, Decker PA, Limper AH. Clinical outcomes of pulmonary Langerhans'-cell histiocytosis in adults. N Engl J Med. 2002 Feb 14;346(7):484-90.